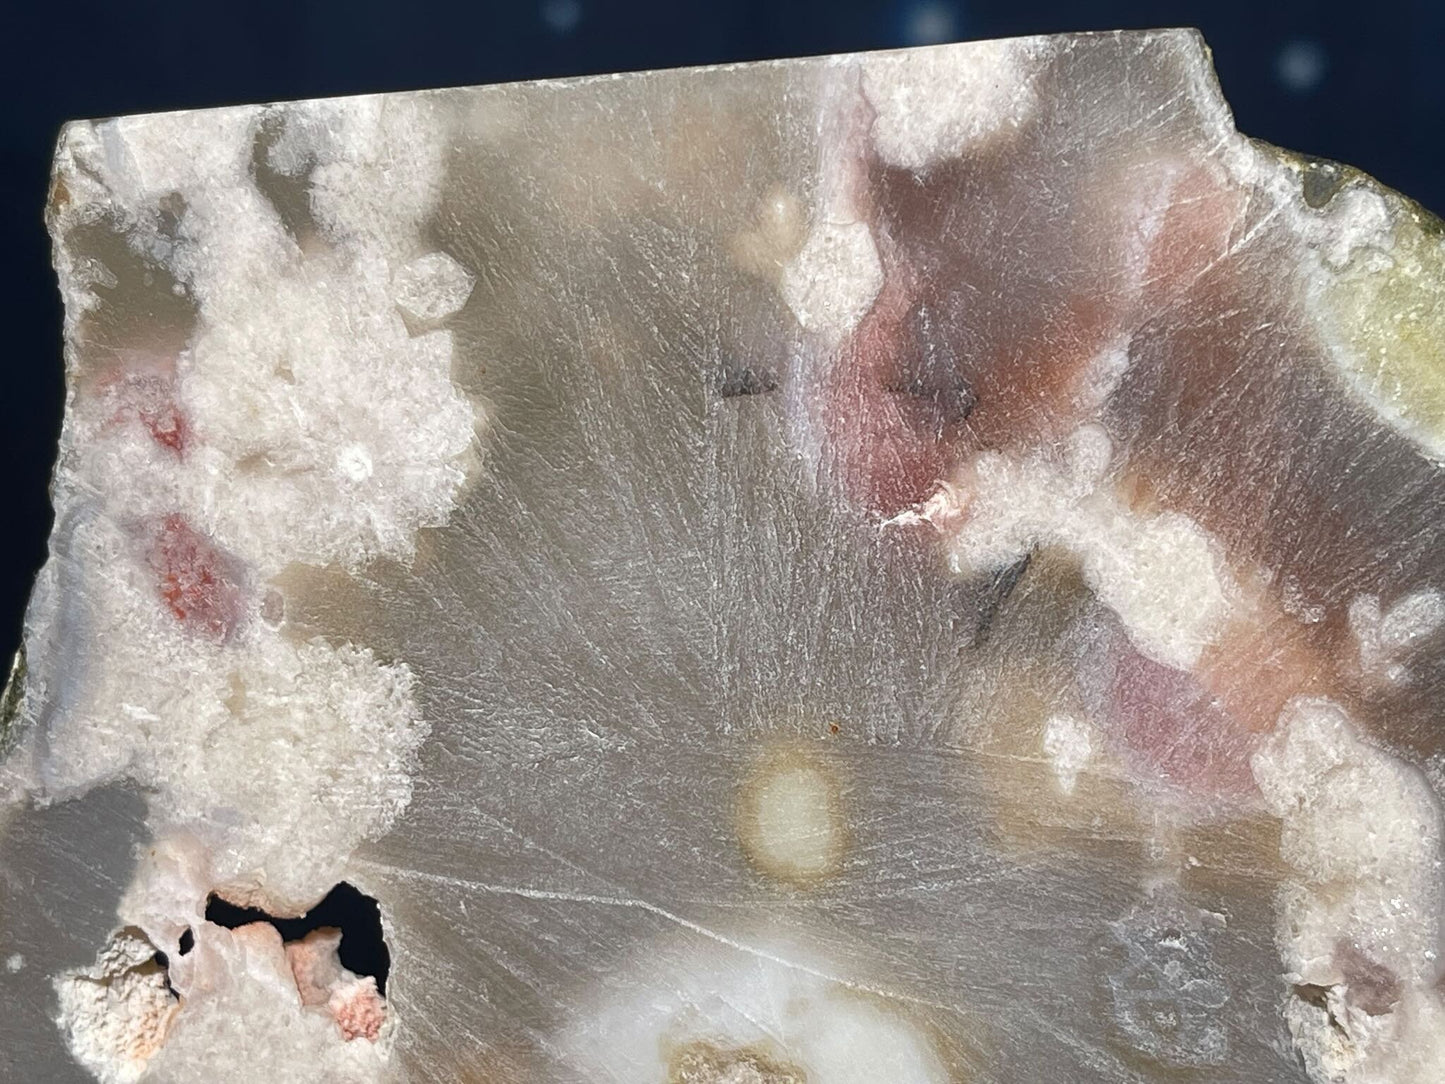
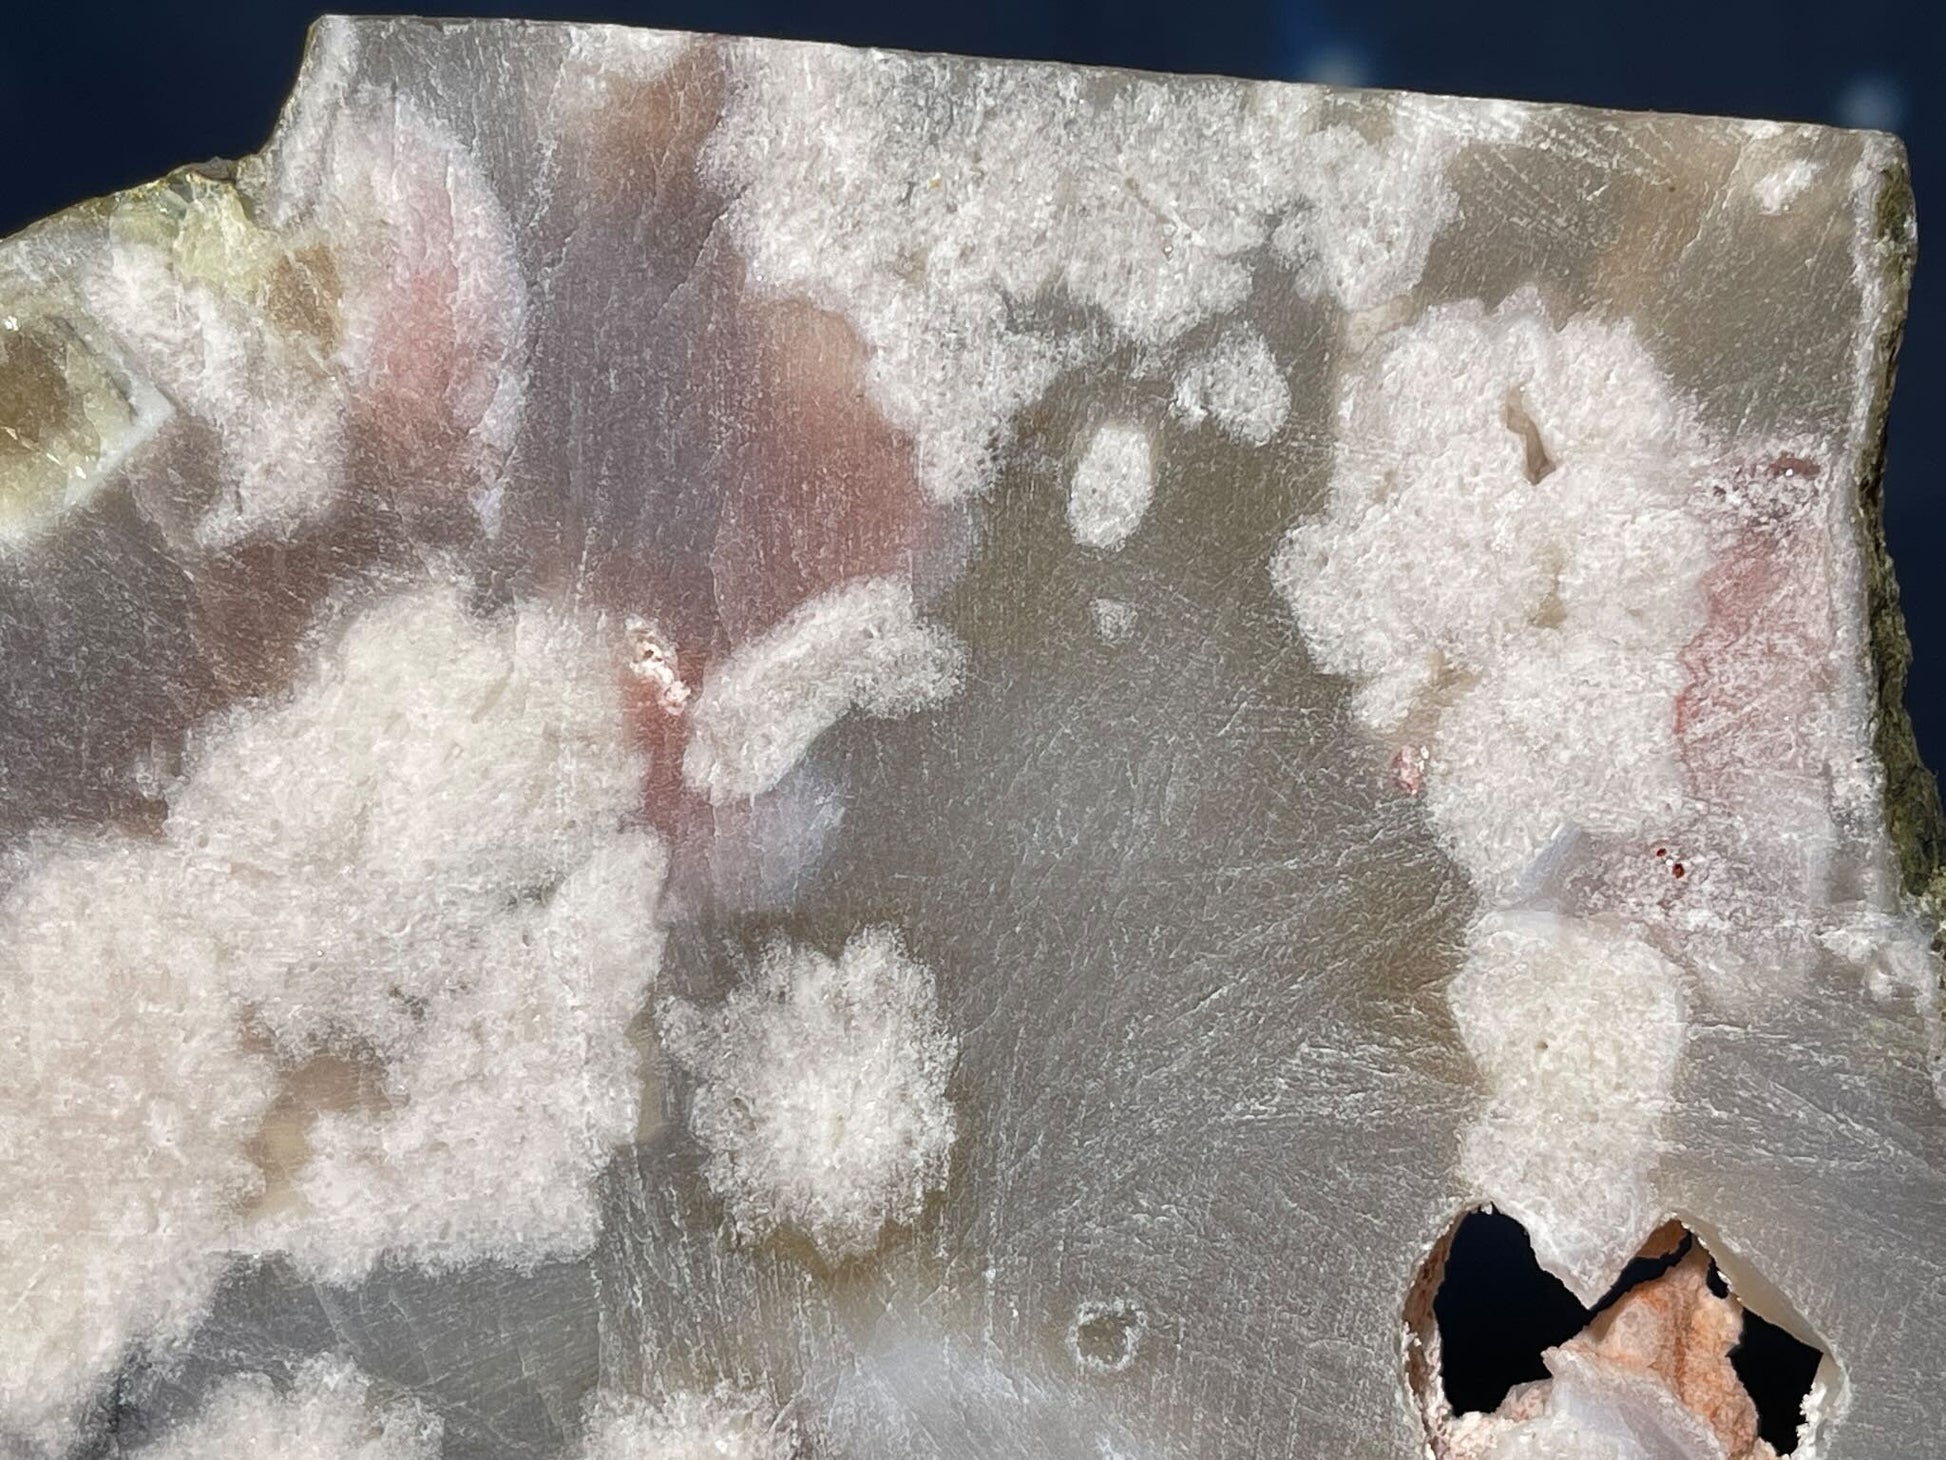
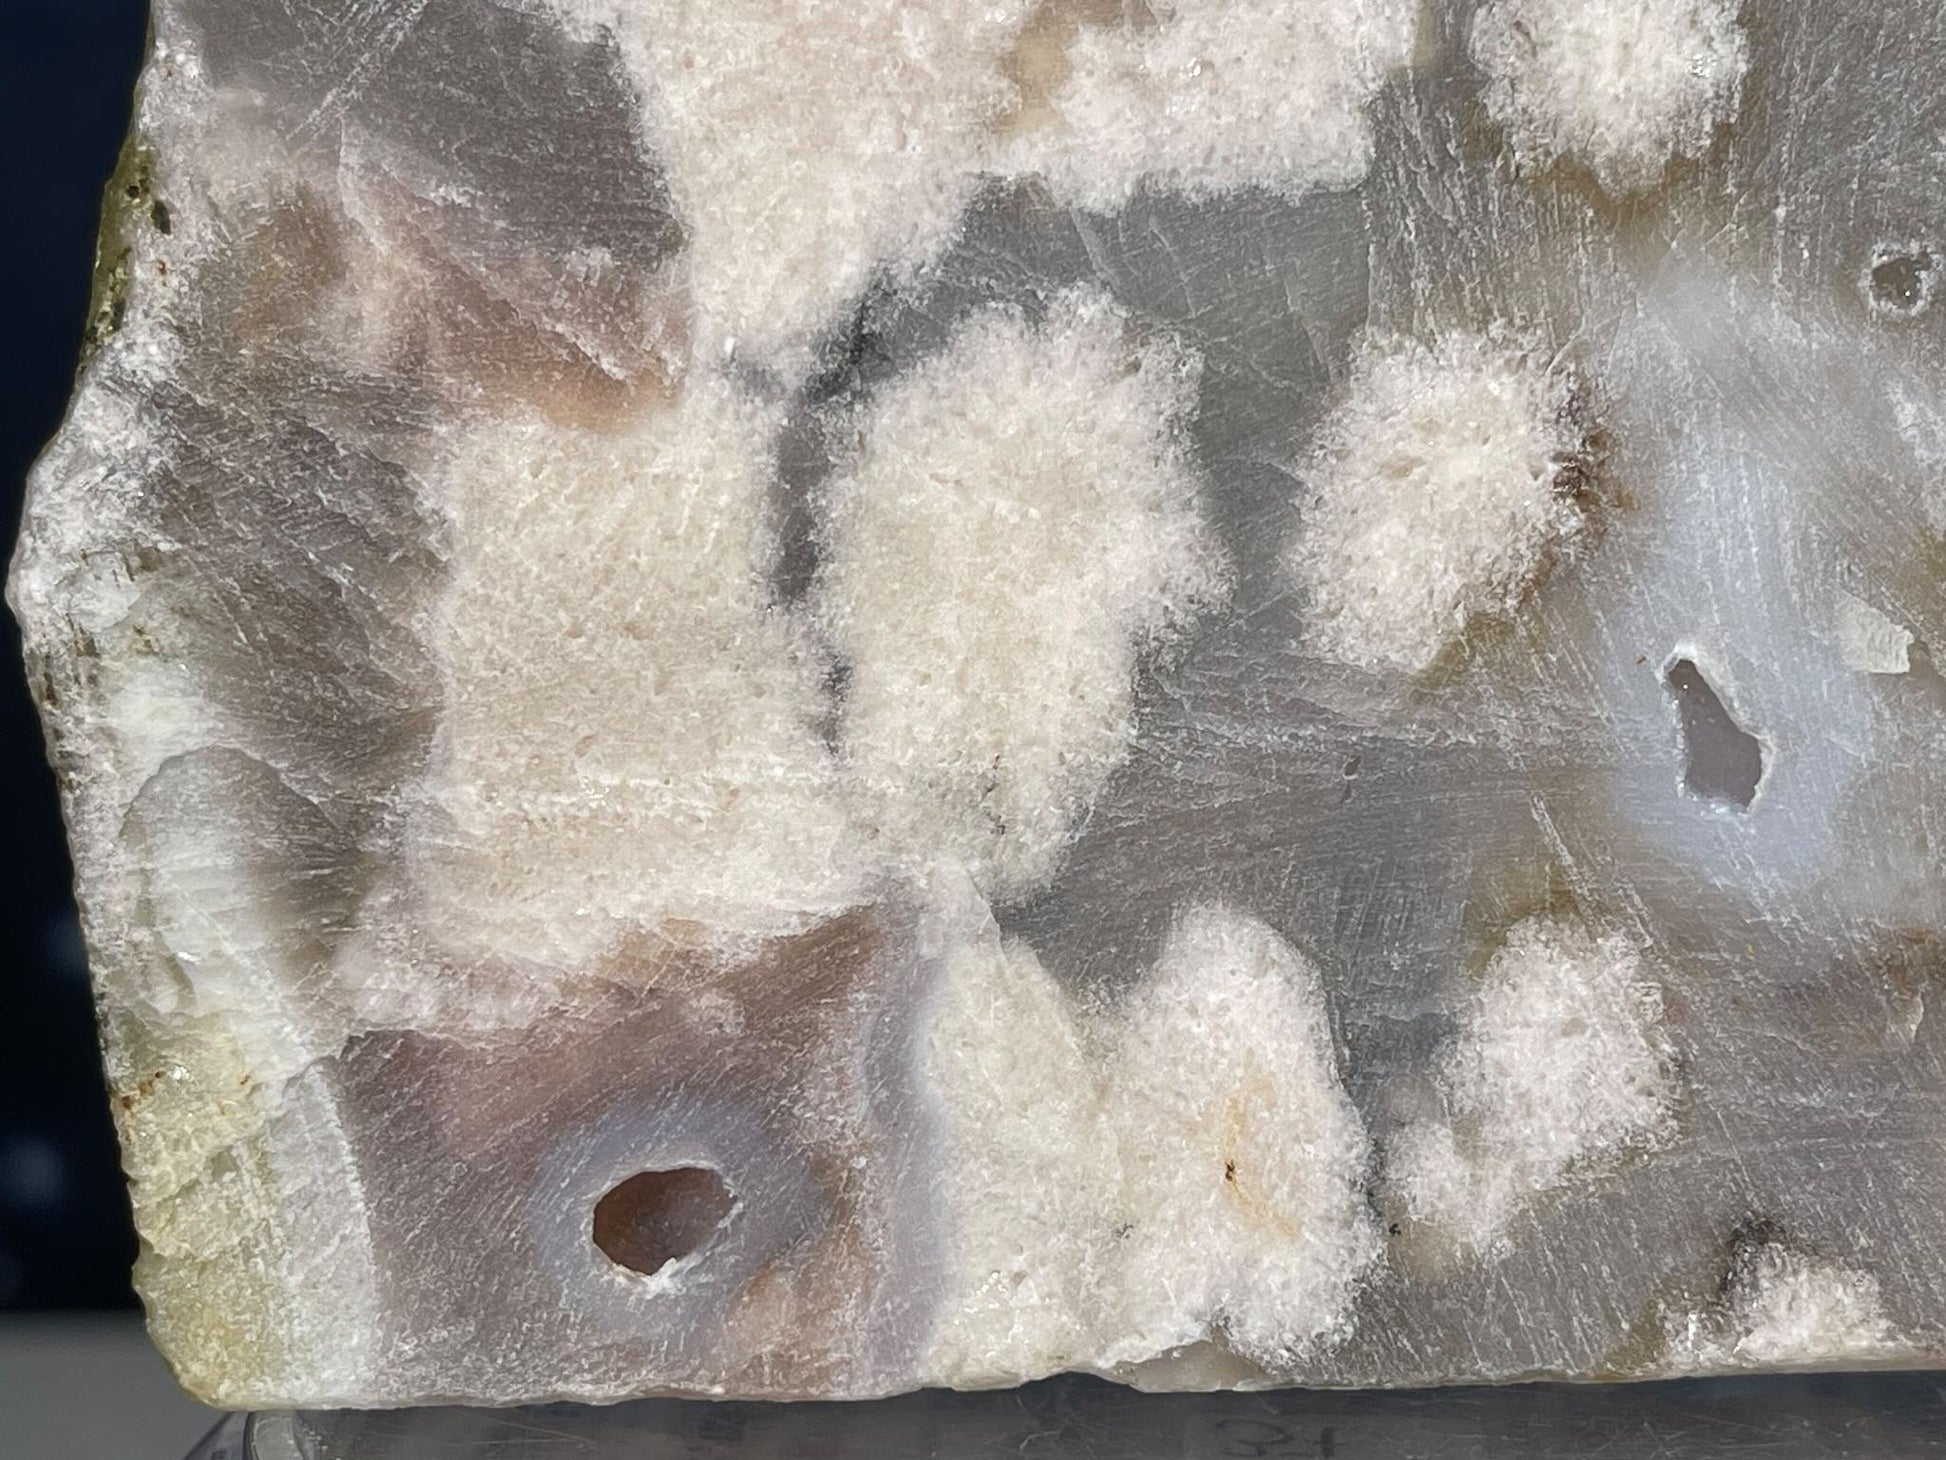

My Store
Flower Agate Slab – Unpolished • 0.258 kg
Flower Agate Slab – Unpolished • 0.258 kg
Couldn't load pickup availability
Share
📸 Listing Details
There is a photo of it backlit to highlight internal details and structure.
Size (Approx.):
• Length: 5"
• Width: 5/8"
• Height: 4"
Net Weight: 9.1 oz =0.258 kg
Origin: Sourced from China
For metaphysical properties, go to the metaphysical tab.
The crystal shown in the photos is the exact piece you’ll receive. I photograph each item with care so that its natural beauty, sparkle, and unique features shine through, just as they do in person.
Before checking out, please take a moment to review the full description, shop FAQs, and store policies—it helps ensure a smooth and enjoyable experience every time. 🩵









Let customers speak for us
from 211 reviewsI absolutely LOVE all my Apophyllite!! All 5 of them!

Items = STUNNING
Packaging =items packaged securely.
Shop/Owner = One of my favorites to shop with
Repeat customer = absolutely 💯

Exceptional service! Highly recommend this shop!💕

Perfect pieces in excellent quality to wire wrap. Top notch seller. 10 out of q0 recommend 🌟🌟🌟🌟
Seller fixed my ordering mistake for me. Very nice skull. Awesome stone. Exactly as expected. Thanks.
Very nice crystal,fast shipping, nice gift, very happy with my order.
Gorgeous piece! Excellent packaging and even gifted some stones! Thank you!!
Looks just like the sugar skull I picked out. Strong magnet, happy with my purchase overall. Love how it looks on my fridge :)
Super smooth transaction, arrived fast and exactly as I expected. Great seller!!
pretty rock, definitely the one shown in the pictures
flashy outside in sunlight :)
not how i thought it’d look indoors so a bit disappointed- not even half as flashy inside, guess that’s on me though for not realizing how strong the photo’s lighting is 😅
very deep blue, almost black inside house
lovely rock :)